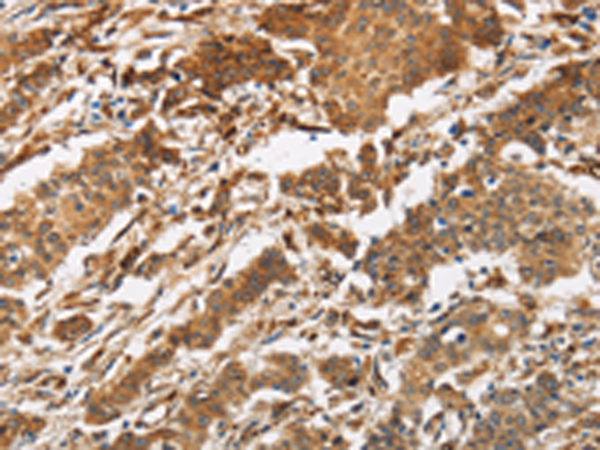
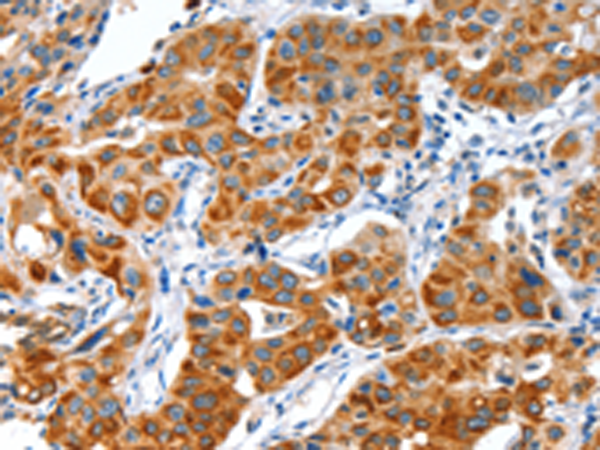
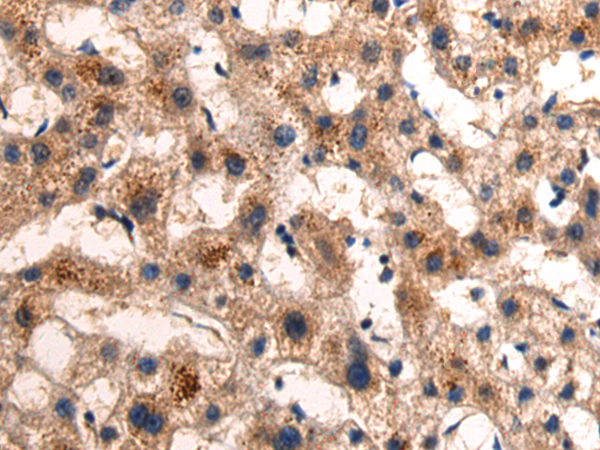
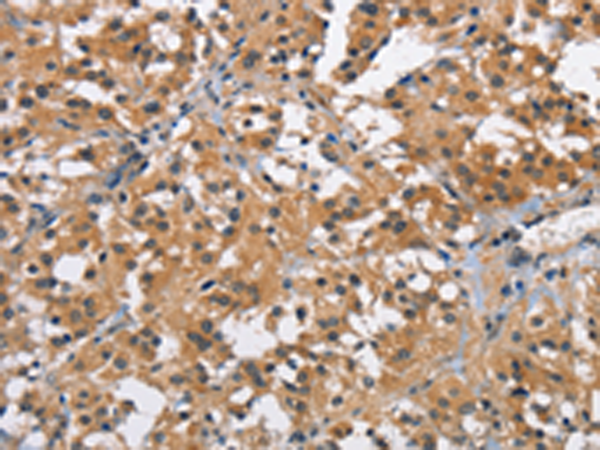

-
分类: 科研抗体货号: P01149别名:应用: IHC反应种属: Human, Mouse, Rat
-
分类: 科研抗体货号: P01101别名: AIP; AKIP; MRP-S38应用: WB反应种属: Human
-
分类: 科研抗体货号: P01124别名: BCSC1; BCSC-1; LOH11CR2A应用: IHC反应种属: Human
-
分类: 科研抗体货号: P01143别名: MO2L; MO25-BETA; bA103J18.3; RP11-103J18.3应用: WB,IHC反应种属: Human, Mouse
-
分类: 科研抗体货号: P01097别名: AGP2; AGP-B; AGP-B'应用: WB,IHC反应种属: Human, Mouse
-
分类: 科研抗体货号: P01122别名: TOK1; TOK-1应用: WB反应种属: Human, Mouse
-
分类: 科研抗体货号: P01142别名: AZ3B; C3AR; HNFAG09应用: WB,IHC反应种属: Human, Mouse
-
分类: 科研抗体货号: P01096别名: AC3应用: WB,IHC反应种属: Human, Mouse, Rat
-
分类: 科研抗体货号: P01120别名: BCT1; PP18; BCATC; ECA39; MECA39; PNAS121应用: WB,IHC反应种属: Human, Mouse
-
分类: 科研抗体货号: P01135别名: BRE; BRCC4; BRCC45应用: WB,IHC反应种属: Human, Mouse, Rat

鄂公网安备42018502007531号
鄂公网安备42018502007531号

